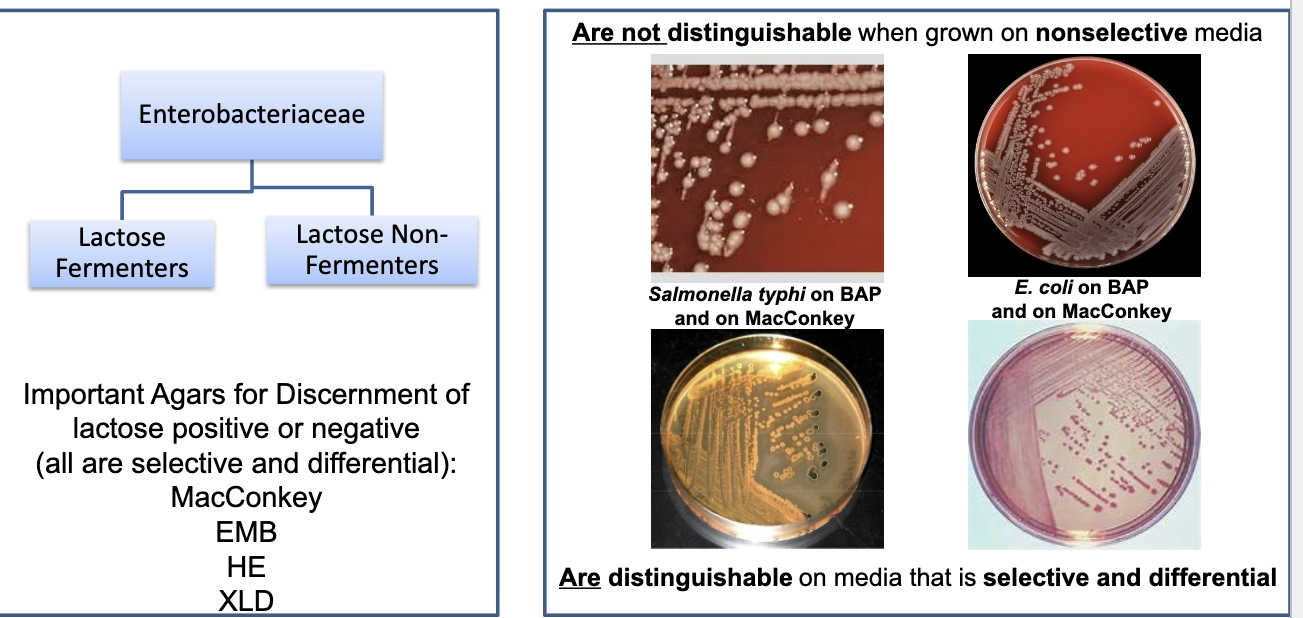

1/15
Looks like no tags are added yet.
Name | Mastery | Learn | Test | Matching | Spaced | Call with Kai |
|---|
No analytics yet
Send a link to your students to track their progress
enteric
relating to or occurring in the intestines
family: enterobacteriaceae
found in soil, water, decaying matter. inhabit the lower alimentary canal (predominantly intestinal tract) of man as normal flora (most are nonpathogenic). referred to as enteric (intestinal) bacteria. some members are most important intestinal pathogens: salmonella (typhoid fever), shigella (bacillary dysentery), yersinia (plague). can be opportunistic pathogens (opportunists), have capability of producing disease in any tissue. can be pathogenic at sites external to GI tract
enterobacteriaceae can be normal flora or pathogenic in the GI tract
this bacteria from fecal (stool) samples needs to be differentiated since GI tract has a lot of normal bacterial flora. are not distinguishable when grown on nonselective media: they all look the same. pathogenic bacteria in fecal samples are lactose negative, so look for lactose negative colonies (lactose positive = pink)
serological typing of strains of bacteria
sub-speciate enteric bacterial pathogens using antibody-based typing. uses K antigen, H antigen, & O antigen

K antigen
capsular (polysaccharide) antigen. best known as Vi antigen of salmonella typhi (has role in pathogenesis of typhoid fever)
H antigen
flagellar (protein) antigen. speciates bacteria in genera salmonella & arizona
O antigen
somatic (“relating to the body”) antigen. used for epidemiologic serological subgrouping. lipopolysaccharide (LPS). this antigen + lipid A = LPS, which is endotoxin
endotoxin
30% of patients with enteric septicemia will develop shock with 40-90%
mortality. defect is inadequate blood supply to vital organs which causes:
• hypoxia – oxygen deficiency in the tissue
• metabolic failure – failure of a metabolic processes
• multiple organ failure – current leading cause of death in intensive care units
enterotoxins
toxins specific for cells of the intestinal mucosa that cause gastrointestinal upset
such as cramps, diarrhea and nausea. exert their toxic effect on intestinal tract. cause transudation into ileum (passage of fluid though membrane or tissue surface to region between small & large intestines), which results in diarrhea & vomiting.
biochemical properties common to all enterobacteriaceae
gram negative rods – gram stain
facultative anaerobes – oxygen requirement
utilize glucose fermentatively with release of acid end products – glucose positive
oxidase negative – lack cytochrome oxidase
nitrate positive – reduce nitrates to nitrites
do not produce spores
escheriacheae tribe
escherichia coli
shigella
escherichia coli (E. coli)
predominant acultative organism that makes up the normal flora of
the large intestine. opportunistic enteric rod that can cause intestinal as well as
extraintestinal infection (UTI, gram - sepsis, meningitis, wounds, pneumonia)

E. coli intestinal infection
lactose negative strains are ones of concern. can produce enterotoxin. can be serologic strain or other pathogenic strains. treated with antibiotics (tends to be susceptible to most antibiotics, some resistance emerging). fluid & electrolyte management appears to be best treatment of diarrhea
shiga toxin-producing E. coli O157:H7 (EHEC)
important pathogen in north america. produces shiga toxin (same toxin produced by shigella dysenteriae). complication: development of hemolytic uremic syndrome (HUS), which results in death or chronic renal disease. transmitted by food, water, direct contact. implicated food products: ground beef, salami, raw milk, alfalfa sprouts, unpasteurized apple cider & juice, contaminated pork, poultry, lamb, bagged fresh spinach

lab ID of EHEC
specialized media, polymerase chain reaction (PCR), agglutination reactions, enzyme-linked immunosorbent assay (ELISA), testing of stool culture (assay uses antibody against toxin to specifically identify antigen in stool specimen)
shigella
all species are human pathogens & cause bacillary dysentery (shigellosis). species differentiated serologically & biochemically. most reported in US is S. sonnei (D). all possess O antigen, some possess K. only O is used in typing. K antigen (capsular) may mask O antigen & must be removed before typing (K is heat labile, O is not, so boil it). all cause severe diarrhea, bacillary dysentery.